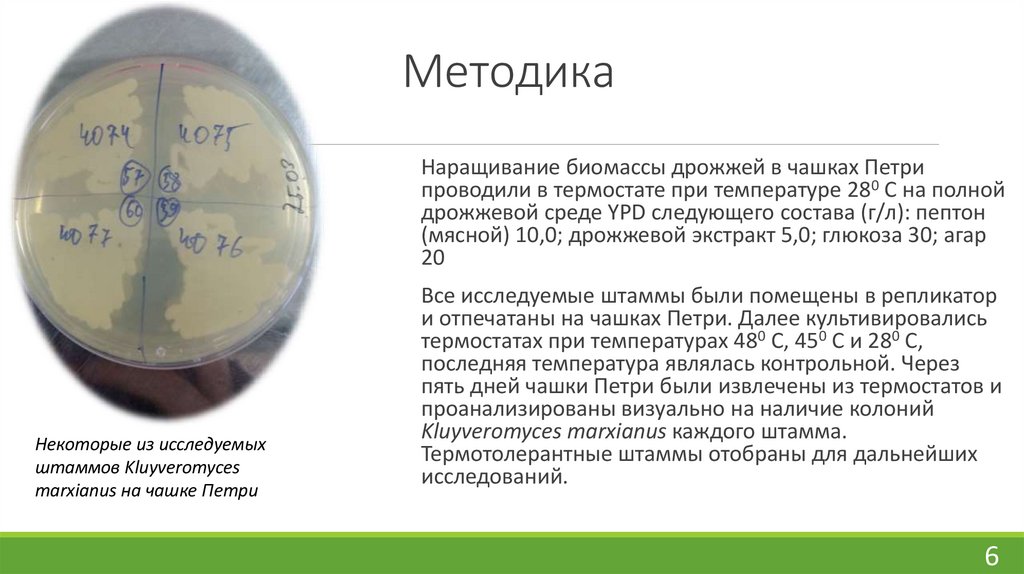
Методика

Similar presentations:
Отчет по технологической и научно-исследовательской практикам
1. Отчет по технологической и научно-исследовательской практикам
МИНИСТЕРСТВО СЕЛЬСКОГО ХОЗЯЙСТВА РОССИЙСКОЙ ФЕДЕРАЦИИФЕДЕРАЛЬНОЕ ГОСУДАРСТВЕННОЕ БЮДЖЕТНОЕ ОБРАЗОВАТЕЛЬНОЕ УЧРЕЖДЕНИЕ ВЫСШЕГО ОБРАЗОВАНИЯ
«РОССИЙСКИЙ ГОСУДАРСТВЕННЫЙ АГРАРНЫЙ УНИВЕРСИТЕТ –
МСХА имени К.А. ТИМИРЯЗЕВА
(ФГБОУ ВО РГАУ – МСХА имени К.А. Тимирязева)
Отчет по технологической и научноисследовательской практикам
На
базе
Биоре сурсного
центра
–
Всеро ссийской коллекции промышленных
микроорганизмов
отдела
ре сурсных
центров Курчатовского комплекса НБИКСприродоподобных технологий
Студентки группы Д-А 408
Носовой С.С.
Москва, 2025
2. Поиск продуцентов этанола среди термотолерантных штаммов дрожжей Kluyveromyces marxianus
АктуальностьЭтанол – одно из самых многофункциональных и широко используемых химических
веществ в мире.
Оптимизация производства этанола привлекает внимание многих исследователей
При культивировании дрожжей выделяется большое количество тепла, поэтому
выгоднее охлаждать среду в биореакторе до более высокой температуры, снижая расход
теплоносителя
Внедрение в промышленность дрожжей, устойчивых к этаноловому стрессу, позволило
бы повысить эффективность и выход этанола, а также снизить риск контаминации
благодаря токсичности спирта
Следовательно, поиск, культивирование и внедрение в промышленное производство
штаммов, обладающих высокой термотолерантностью и устойчивостью к содержанию
этанола в среде экономически и экологически выгодно.
2
3. Цель и задачи
Цель:Задачи:
Отобрать
термотолерантные штаммы
дрожжей
Kluyveromyces
marxianus для дальнейших
исследований и определить
предельную концентрацию
спирта, при которой могут
расти
дрожжи
Kluyveromyces marxianus.
1. Вскрыть 152 ампулы с лиофилизированными
штаммами дрожжей Kluyveromyces marxianus
2. Провести тесты на термотолерантность для 152
штаммов; предварительно оценить количество
спирта, продуцируемого ими
3. Выбрать один из отобранных в предыдущем
опыте штаммов дрожжей Kluyveromyces
marxianu
4. Проверить, при какой концентрации спирта
останавливаются
процессы
его
жизнедеятельности
3
4. Объект и материалы исследования
Объект исследования – аскомицетовые дрожжи Kluyveromycesmarxianus
Питательная среда YPD
Качалка Inforce Multitron-HT
Спектрофотометр DRAWELL при длине волны λ=600 нм
4
5. На способность образовывать устойчивые колонии при температуре 480 С проверяли следующие штаммы дрожжей
Y-10, 18, 84, 86, 130, 132, 204, 205, 206, 207, 209, 240, 256, 265, 302, 303, 320, 423, 485,487, 488, 629, 630, 631, 632, 662, 681, 719, 724, 763, 929, 1032, 1171, 1325, 2034, 2038,
2039, 2041, 2042, 2137, 2138, 3101, 3240, 3514, 3515, 3565, 3969, 4030, 4062, 4063,
4064, 4065, 4070, 4071, 4072. 4073, 4074, 4075, 4076, 4077, 4078, 4079, 4080, 4081,
4082, 4083, 4084, 4085, 4086, 4087, 4088, 4089, 4090, 4091, 4092, 4093, 4094, 4095,
4104, 4108, 4109, 4110, 4111, 4112, 4113, 4114, 4115, 4116, 4117, 4165, 4182,
4253,4254, 4256, 4258, 4267, 4268, 4290, 4308, 4458, 4507, 4540, 4541, 4542, 4543,
4544, 4545, 4546, 4547, 4548, 4549, 4550, 4551, 4552, 4553, 4554, 4555, 4556, 4557,
4566, 4567, 4568, 4569, 4570, 4571, 4572, 4573, 4574, 4575, 4589, 4590, 4591, 4592,
4593, 4594, 4595, 4596, 4597, 4598, 4617, 4631, 4803, 4804, 4805, 4857, 5239, 5240,
5241, 5273, 5276, 5288, 5290.
Всего 152 штамма
5
6. Методика
Наращивание биомассы дрожжей в чашках Петрипроводили в термостате при температуре 280 С на полной
дрожжевой среде YPD следующего состава (г/л): пептон
(мясной) 10,0; дрожжевой экстракт 5,0; глюкоза 30; агар
20
Некоторые из исследуемых
штаммов Kluyveromyces
marxianus на чашке Петри
Все исследуемые штаммы были помещены в репликатор
и отпечатаны на чашках Петри. Далее культивировались
термостатах при температурах 480 С, 450 С и 280 С,
последняя температура являлась контрольной. Через
пять дней чашки Петри были извлечены из термостатов и
проанализированы визуально на наличие колоний
Kluyveromyces marxianus каждого штамма.
Термотолерантные штаммы отобраны для дальнейших
исследований.
6
7. Исследование устойчивости к этанолу
Наращивание биомассы дрожжей Kluyveromyces marxianusштамм Y-5288 непосредственно перед исследованием
производили в колбах объемом 750 мл с 50 мл среды
проводили на качалке Inforce Multitron-HT с жидкой средой
YPD при 200 об/мин и 300 С в течение суток.
В колбу 750 мл помещали 30 мл жидкой питательной среды
YPD, затем добавляли спирт в следующих количествах (г/л):
20, 30, 40, 50, 60, 70, 80, 90, 100, 110, 120, 130, 140, 150.
Также была контрольная колба, не содержащая спирта. В
каждую колбу помещали полную петлю биомассы дрожжей
и культивировали на качалке Inforce Multitron-HT в течение
пяти суток. Прирост биомассы измеряли с помощью
спектрофотометра DRAWELL при длине волны λ=600 нм на
вторые и пятые сутки.
Дрожжи Kluyveromyces marxianus
штамм Y-5288 в посевных колбах
7
8. Результаты
По итогам проведенных тестов следующие штаммы ВКПМ продемонстрироваливысокую термотолерантность и были отобраны для дальнейших опытов: Y-10, 130,132,
204, 205, 265, 302, 763, 2138, 3101, 3515, 4030, 4507, 4550, 4557, 4566, 4574, 4592, 4595,
4617, 4631, 5288, 5290
Штамм ВКПМ Y-5288 при изначальной концентрации этанола в среде от 20 до 70 г/л
растет лучше, чем без добавления спирта в среду
При концентрации этанола 100 г/л наблюдался прирост биомассы в среднем в три
раза
При концентрации спирта большн 100 г/л роста не наблюдается.
Таким образом, можно сказать, что 100 грамм этанола на литр среды – предельно
допустимая концентрация для Kluyveromyces marxianus
8
9. Выводы
Был проведен предварительный отбор термотолерантных штаммов для дальнейшей работы.Из всех исследуемых 152 штаммов 23 показали способность расти при температуре 480 С.
Был выявлен предел устойчивости одного штамма Kluyveromyces marxianus к концентрации
спирта в среде.
˅ Задачи, поставленные в исследовании, выполнены
Необходимо:
Провести дальнейшие работы по исследованию свойств избранных штаммов и последующего
отбора из них наиболее перспективных для использования в промышленности
Исследовать пределы устойчивости к этанолу у остальных термотолерантных штаммов
Kluyveromyces marxianus
9

industry
industry








